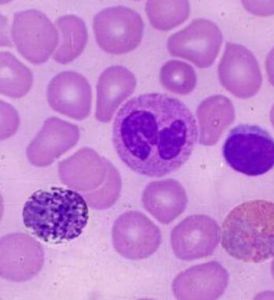
紅細胞基質

簡介
細胞基質又稱細胞液(cytosol),為將細胞質中顆粒部分除去後剩下的均一性物質。分布在細胞表面,粘度較高的基質稱為外質(exoplasm)。分布在細胞內部,粘度較低的基質稱為內質(endoplasm)。
細胞質基質也稱為細胞漿,是富含蛋白質(酶)、具有一定粘度、能流動的、半透明的膠狀物質。它是細胞重要的組分,具有以下功能:
(1)代謝場所很多代謝反應如糖酵解、戊糖磷酸途徑、脂肪酸合成、蔗糖的合成等都在細胞質基質中進行,而且這些反應所需的底物與能量都由基質提供。
(2)維持細胞器的結構與功能細胞質基質不僅為細胞器的實體完整性提供所需要的離子環境,供給細胞器行使功能所必需的底物與能量,而且流動的細胞基質十分有利於各細胞器與基質間進行物質與能量的交換。
紅細胞(Erythrocytes)。紅細胞在常規化驗英文長縮寫成RBC
在所有的脊椎動物及若干無脊椎動物,其血紅素(無脊椎動物也有時是蚯蚓紅血朊)包含在特定的細胞中來進行其機能活動,這種血球稱為紅細胞,或稱紅血球,是血液中數量最多的一種血細胞,同時也是脊椎動物體內通過血液運送氧氣的最主要的媒介。其它的血細胞,如白血球,則是免疫細胞。
紅細胞中含有血紅蛋白,因而使血液呈紅色。血紅蛋白能和空氣中的氧結合,因此紅細胞能通過血紅蛋白將吸入肺泡中的氧運送給組織,而組織中新陳代謝產生的二氧化碳也通過紅細胞運到肺部並被排出體外。血紅蛋白更易和一氧化碳相合,當空氣中一氧化碳和含量增高時,可引起一氧化碳中毒。
紅細胞和血紅蛋白的數量減少到一定程度時,稱為貧血。紅細胞大量被破壞可引起溶血性黃疸。
紅細胞描述:多,小而圓,中央著色較淺,無核。